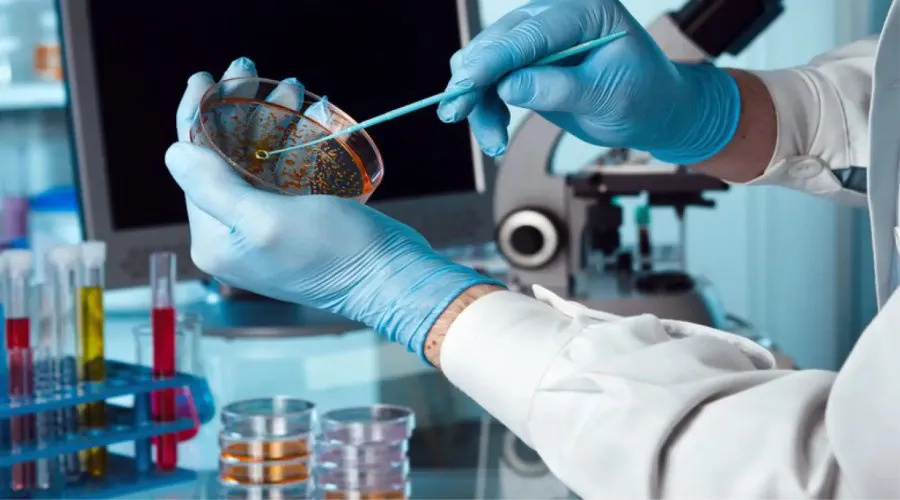
biotecnologia-industrial-aplicacion

En el marco del Día Internacional de la Biotecnología, Mendoza relanzó su estrategia para posicionarse como un nodo clave en el desarrollo de este sector. Con el inicio del Ciclo de Bionegocios, la provincia reunió a referentes nacionales, instituciones académicas, organismos públicos y empresas emergentes con el objetivo de impulsar un ecosistema innovador, capaz de generar soluciones en salud, alimentación, energía y ambiente.
Durante el evento, se presentaron los Lineamientos Prospectivos del Ecosistema Biotecnológico de Mendoza al 2030, una hoja de ruta construida de forma colaborativa que propone metas concretas en torno a cinco ejes estratégicos: infraestructura y financiamiento, formación de talento, articulación institucional, políticas públicas y la creación de un HUB BIO provincial. La ambición es clara: convertir a Mendoza en un referente regional con impacto global.
Entre las experiencias analizadas se destacó el modelo del HUB BIO de Santa Fe, que sirvió como ejemplo para adaptar buenas prácticas al contexto local. También se remarcó la necesidad de consolidar alianzas entre universidades, empresas, el Estado y el sistema científico para acelerar resultados sin repetir errores.
A futuro, la provincia proyecta avanzar con una ley de promoción biotecnológica, carreras universitarias específicas, un Parque Biotech y el fortalecimiento de startups como Epiliquid, Bioeutectics y ZaviaBio. Con estos pasos, Mendoza busca transformar conocimiento en desarrollo sostenible y crecimiento económico basado en la innovación.






